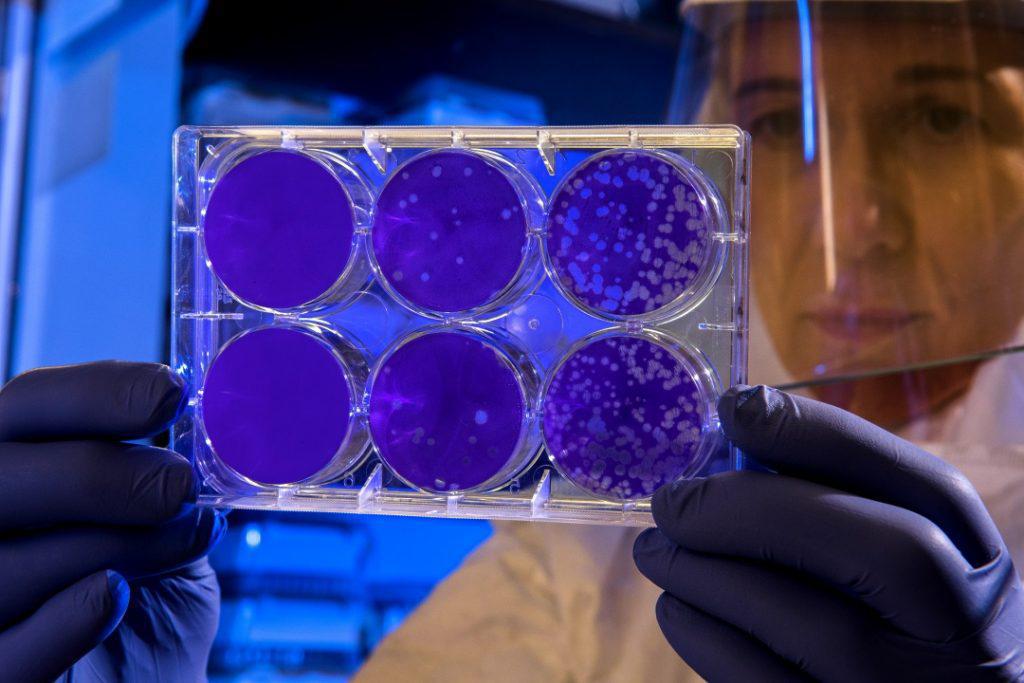

Αρνητικά τρία ύποπτα κρούσματα κορoναϊού στη Χαλκιδική
Όπως προέκυψε από τον σχετικό εργαστηριακό έλεγχο.
Αρνητικά είναι τα αποτελέσματα των τεστ που συντελέστηκαν για τρεις ασθενείς που προσήλθαν στο Γενικό Νοσοκομείο Χαλκιδικής, προκειμένου να διαπιστωθεί εάν είναι θετικοί στον κοροναϊό.
Όπως μεταδίδει το halkidikifocus.gr, μέχρι και αυτήν την ώρα, πάντως, αναμένονται τα αποτελέσματα ενός τέταρτου περιστατικού με επιδημιολογικό ιστορικό από την Αγγλία.
Σημειώνεται ότι, το πρώτο επιβεβαιωμένο κρούσμα στην περιοχή επιβεβαιώθηκε σε μοναχό της Ιεράς Μονής Ξενοφώντος του Αγίου Όρους.
Σχετικά Αρθρα
